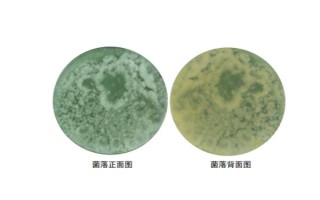
如何用大豆巧制氨基酸叶面肥，大豆粉和发酵菌剂的比例为1:100

大青叶冬天会不会冻死,在冬天可以正常生长不会被冻死
大青叶冬天不会冻死,因为大青叶的耐寒能力较强。温度:大青叶喜温暖环境,生长适温15-28℃,温度低于零下20℃时出现冻害。湿度:大青叶喜湿润环境,耐旱,适宜空气湿度70-75%,土壤湿度过大时易烂根。...
08-24
1、准备:准备好大缸及大豆粉。
2、菌剂用量:按大豆粉和发酵菌剂按一定比例混匀。
3、物料加水:往大豆粉中加入糖醋水,并调节含水量。
4、放置座菌:物料自然放置12小时左右。
5、发酵:将物料转移至大缸中堆积发酵,当累计发酵温度达一定程度时翻倒。发酵后,翻动发酵料并晾干。
6、浸泡提取:将物料转移至容器中并用红糖水浸泡,提取氨基酸水。

1、准备
(1)首先准备好发酵所需的水泥池或大缸。
(2)称量好发酵用大豆粉重量,并测定其含水量,通常含水量为12%。

2、菌剂用量
按1:100比例,即100公斤大豆粉,拌1公斤金宝贝发酵菌剂,一定要搅拌均匀,此过程可称为菌剂接种。

3、物料加水
(1)往接种完菌剂的大豆粉中加入糖醋水,将大豆粉物料的含水量调到55-60%。
(2)调整方式:因含水率12%的100公斤大豆粉本身自带水分约12公斤,再外加48公斤的糖醋水,总计含水约50公斤。
(3)糖醋水的制作方法:将5%的红糖水和3%米醋兑成所需加水量即可。

4、放置座菌
将调好含水量的大豆粉物料,自然放置12小时,这一过程可称为“座菌”。
5、开始发酵
(1)将自然放置的待发酵物料及时移到水泥池或大缸堆积发酵。为保证通气,堆积厚度通常不超过50㎝为好,堆积完毕后,上面盖上纱布或塑料布,并注意做到保温、保湿、保洁。
(2)发酵开始后,7-10天的发酵温度应保持在20-25℃以上,累计发酵温度达300-400℃时,可翻倒一次,翻动后立刻盖上覆盖物,促使其继续发酵,等到累计发酵温度达到600℃以上(20-25天),发酵料成块,臭味基本消失,可停止发酵,及时把发酵料翻动,晾干一天(含水量为40-45%)。

6、浸泡提取
(1)将晾干后的发酵物料移到容器里,用5%红糖水浸泡,即可提取氨基酸水。
(2)浸泡比是1公斤大豆粉加5%红糖水5公斤,浸泡时间为5-15天,浸泡完毕(没臭味,液体呈深棕色),应及时用真空泵提取氨基酸水,做好包装,在阴凉处保管即可。

1、叶菜类蔬菜通常在生长前期和中期施用,茄果类、瓜类、豆类、根茎类一般在中期和后期施用。
2、氨基酸叶面肥喷施次数要适当,通常叶面追施进行2-3次即可,每7-10天进行一次。
标签: 如何用大豆巧制氨基酸叶面肥
相关文章
大青叶冬天不会冻死,因为大青叶的耐寒能力较强。温度:大青叶喜温暖环境,生长适温15-28℃,温度低于零下20℃时出现冻害。湿度:大青叶喜湿润环境,耐旱,适宜空气湿度70-75%,土壤湿度过大时易烂根。...
08-24
金鱼共分为四大类,分别为是草种金鱼、文种金鱼、蛋种金鱼和龙种金鱼,其中文种金鱼和蛋种金鱼性格温和,可以混养。草种金鱼体型偏大,性情较为凶猛,不适合与其他金鱼混养。龙种金鱼两个眼睛比较突出,若与其他金鱼...
07-17
小麦赤霉病的症状主要包括苗腐、穗腐、茎基腐。苗腐:种芽变褐,根冠腐烂,导致幼苗黄瘦或死亡。在湿度较大的情况下,枯死苗会出现粉红色的霉状物。穗腐:小穗、颖片上出现水浸状病斑,颜色多为浅褐色。病斑会慢慢蔓...
08-05
巨骨舌鱼在8月份浅滩产卵,每次约16万卵,通常分数次产下,3-5天孵化,雌性产卵后离开,而雄鱼则留守保护幼鱼。雄鱼尾部变红从而保护卵和照顾幼鱼,幼鱼和雄鱼头部为黑色,而幼鱼常围绕雄鱼,不愿离去。雄鱼照...
06-02
母鸡的鸡冠很大一般不正常。鸡冠的大小取决于鸡体内含有多少雄性激素,当母鸡体内的雄性激素过多时,鸡冠就会变大。鸡冠呈肉质隆起状,附近无毛。通常公鸡的鸡冠要大于母鸡,可以此判断雄性激素的多少。白洛克品种的...
07-07
味道区别:洋姜又叫菊芋,性凉,味道甘苦,生姜味道芳香,并且有独特的辛辣味。用途区别:洋姜可以用来熬粥,也可以制成咸菜,还可以制取淀粉和酒精原料,生姜可以用来煎汤,如果是仔姜,还可以当菜使用,但需注意不...
01-04
土壤:以酸性或微碱性的土壤为宜,pH值为5.0-8.0之间都适合栽培。温度:野樱莓耐寒,可在零下20℃生长,适合生长温为18-22℃之间。水分:野樱莓水分需求较小,比较耐旱,不可积水,可多次少量浇水。...
10-03
热门柑橘苗有沃柑、红美人、耙耙柑、皇帝柑、砂糖橘、纽荷尔脐橙等品种。沃柑:结果时间早,成熟时间晚,产量较高,口感较好,在市场上很受欢迎,1斤通常可超过5元。红美人:果实呈圆形,表面光滑,平均重量为20...
07-14
5号秋田狐钩一般搭配1.5号主线+1号子线作钓。5号秋田狐钩钩身长11mm、钩门宽4.5mm、钩底深5mm、钩条径0.34mm、拉力值3.4-4.2kg,适合用于垂钓重量在0.5kg以内的鱼。若为鱼不...
09-03
之所以在夜间杀蓝藻是因为蓝藻大量爆发时,会在夜间时分导致水体缺氧。预防方法:保持池塘底部清爽,同时使用白金底改、黑底净、速净解毒底改、氧化解底安等氧化型底改剂对水体底部环境进行改造。蓝藻爆发原因:未经...
08-10
热点文章
富尔5152玉米栽培技术要点,种植密度每亩5500株
不锈钢锅能不能长期放醋,不可长期盛放
凤尾竹冬季如何浇水,凤尾竹不耐严寒怕冻
扬麦21小麦栽培技术要点,该品种表现幼苗直立
L2318玉米栽培技术要点,适宜播种期4月下旬至5月上旬
工厂化生产番茄每平方米面积的产量,一般可以超过30公斤
吉育654大豆栽培技术要点,高抗大豆灰斑病
碗莲入泥定植的方法,将种子播入花土中再浇水淹没